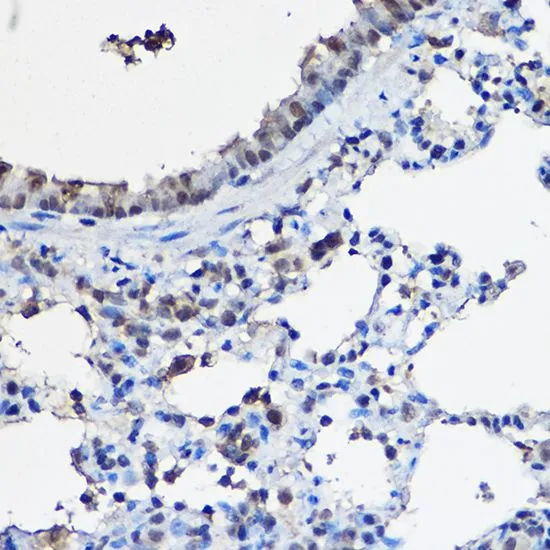

WB analysis of normal (control) and knockout (KO) 293T cell lysate using GTX35206 NCOA2 antibody. Dilution : 1:1000 Loading : 25microg per lane
NCOA2 antibody
GTX35206
ApplicationsWestern Blot, ImmunoHistoChemistry, ImmunoHistoChemistry Paraffin
Product group Antibodies
TargetNCOA2
Overview
- SupplierGeneTex
- Product NameNCOA2 antibody
- Delivery Days Customer9
- Application Supplier NoteWB: 1:500 - 1:2000. IHC-P: 1:50 - 1:200. *Optimal dilutions/concentrations should be determined by the researcher.Not tested in other applications.
- ApplicationsWestern Blot, ImmunoHistoChemistry, ImmunoHistoChemistry Paraffin
- CertificationResearch Use Only
- ClonalityPolyclonal
- ConjugateUnconjugated
- Gene ID10499
- Target nameNCOA2
- Target descriptionnuclear receptor coactivator 2
- Target synonymsGRIP1, KAT13C, NCoA-2, SRC2, TIF2, bHLHe75, nuclear receptor coactivator 2, class E basic helix-loop-helix protein 75, glucocorticoid receptor-interacting protein-1, p160 steroid receptor coactivator 2, transcriptional intermediary factor 2
- HostRabbit
- IsotypeIgG
- Protein IDQ15596
- Protein NameNuclear receptor coactivator 2
- Scientific DescriptionThe protein encoded by this gene functions as a transcriptional coactivator for nuclear hormone receptors, including steroid, thyroid, retinoid, and vitamin D receptors. The encoded protein acts as an intermediary factor for the ligand-dependent activity of these nuclear receptors, which regulate their target genes upon binding of cognate response elements. This gene has been found to be involved in translocations that result in fusions with other genes in various cancers, including the lysine acetyltransferase 6A (KAT6A) gene in acute myeloid leukemia, the ETS variant 6 (ETV6) gene in acute lymphoblastic leukemia, and the hes related family bHLH transcription factor with YRPW motif 1 (HEY1) gene in mesenchymal chondrosarcoma. Alternative splicing results in multiple transcript variants. [provided by RefSeq, Mar 2016]
- Storage Instruction-20°C or -80°C,2°C to 8°C
- UNSPSC12352203